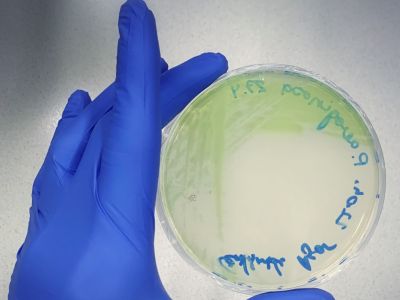
2

KOMBINATORISCHE TOXIZITÄTSTESTS UND INFEKTIONSMODELL
Toxikologische Analyse von Lebens- und Futtermittel und Identifizierung pflanzlicher, antimikrobieller Wirkstoffe

C. elegans unter dem Mikroskop
Foto: Georg Sandner
Agarplatte mit Pathogenen
Foto: Georg Sandner

Pipettieren qPCR Platte
Foto: Georg Sandner
Lebens- und Futtermittelsicherheit ist ein allgegenwärtiges Thema in unserer modernen Gesellschaft. Die Zahl der zu prüfenden Substanzen nimmt in verschiedensten Industriefeldern ständig zu. Außerdem müssen lebensmittelbedingte Verunreinigungen oder Toxine vermieden werden, um eine hohe Qualität der Produkte sowie Konsumentensicherheit zu gewährleisten. Die derzeitigen Ansätze sind insgesamt sehr zeitaufwändig, teuer und durchgeführte Tierversuche führen weiters zu ethischen Debatten. Daher ist es von großem Interesse, geeignete Alternativen in diesem Forschungsbereich zu etablieren.
In diesem Zusammenhang sind in-vitro-Zellkulturen und in-vivo-Modellorganismen von Relevanz. Im Vergleich zu Tierversuchen sind diese Systeme vergleichsweise kostengünstig, erreichen einen mittleren bis hohen Durchsatz und ausgewählte Ergebnisse korrelieren mit Literaturdaten aus Tierstudien. Der Fadenwurm Caenorhabditis elegans (C. elegans) weist beispielsweise eine große Genhomologie und konservierte Stoffwechselwege im Vergleich zu höheren Organismen auf. Daher sind die generierten Daten für die zuverlässige Vorhersage von Substanzeffekten von großer Bedeutung. Außerdem können beteiligte molekulare Wirkweisen im Detail verstanden werden.
Darüber hinaus stellen bakterielle Infektionen und antibiotikaresistente Mikroorganismen ein aktuelles Problem für die Lebens- und Futtermittelindustrie dar. In diesem Zusammenhang wurden bereits antibiotische Leistungsförderer oder der pharmakologische Einsatz von Zinkoxid von der EU verboten. Damit steigt der Druck auf die Produzenten, (natürliche) Alternativen zu suchen.
In diesem Zusammenhang gewinnen sekundäre Pflanzeninhaltsstoffe (Phytochemikalien) immer mehr an Bedeutung, da sie allgemein für ihre antioxidative oder antibakterielle Wirkung bekannt sind.
Ziel dieser Arbeit ist die Etablierung eines Infektionsmodells mit C. elegans und einer Toxizitätsscreening-Plattform mit einfachen Eukaryoten. Kombinierte synergistische oder antagonistische Effekte von Mykotoxinen und Fungiziden auf die allgemeine Zellfitness und epigenetische Effekte werden in einem Hochdurchsatzverfahren getestet. Darüber hinaus wird der Fadenwurm C. elegans mit relevanten Krankheitserregern der Futtermittelindustrie infiziert. Zur Feststellung einer bakteriellen Infektion werden verlässliche Readout-Parameter ermittelt. Phytochemikalien werden anschließend als potenzielle natürliche antimikrobielle Substanzen untersucht.
Lead Researcher:

FH-Prof. Priv.-Doz. Dr. Julian Weghuber
FFoQSI Area Leader GREEN
Leiter CoE Lebensmitteltechnologie und Ernährung
Lebensmitteltechnologie und Ernährung an der FH Oberösterreich
julian.weghuber@fh-wels.at
+43 5 0804 44403
www.fh-ooe.at
